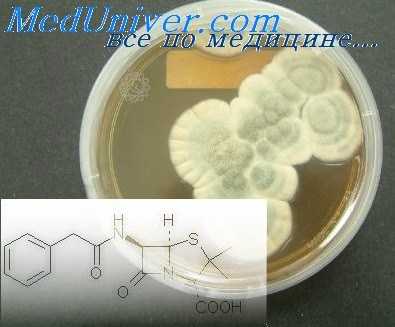
отогенный менингит

Профилактика отогенного менингита. Борьба с ушным менингитом
Добавил пользователь Владимир З. Обновлено: 28.11.2025
Менингит — это бактериальное или вирусное воспаление мягкой мозговой оболочки. Менингит при отите (отогенный) возникает в результате распространения инфекции в субарахноидальное пространство из полостей среднего и внутреннего уха или является следствием других внутричерепных осложнений (экстра-, субдуральный или мозговой абсцесс, тромбоз сигмовидного синуса).
Наиболее частыми возбудителями менингита при отите служат кокки (стрепто-, стафило-, дипло- и пневмококки), значительно реже — другие виды микробов. Однако нередко в спинномозговой жидкости не удается выявить какую-либо микрофлору.
Чаще всего инфекция при отогенном менингите распространяется контактным или лабиринтогенным путем. При первом обычно имеются выраженные изменения вплоть до разрушения в кости, отделяющей полости среднего уха от мозговых оболочек. При этом иногда лептоменингиту предшествует воспаление твердой мозговой оболочки (эпидуральный или субдуральный абсцесс). При лабиринтогенном менингите инфекция из пораженного лабиринта распространяется через водопроводы улитки и преддверия и внутренний слуховой проход. Этот путь инфекции при менингите встречается чаще, чем при других внутричерепных осложнениях.
Менингит возникает обычно при мастоидите, осложняющем острый гнойный средний отит, и хроническом гнойном отите (эпитимпаните), особенно осложненном холестеатомой.
В начальной стадии острого воспаления среднего уха менингит чаще всего является следствием гематогенного распространения инфекции (по сосудистым путям). Это так называемая молниеносная форма менингита, наиболее неблагоприятная. Патологическая анатомия. Начальные воспалительные изменения мягких мозговых оболочек (гиперемия, отечность) распространяются и на кору головного мозга. Серозный экссудат в субарахноидальном пространстве при менингите становится в дальнейшем гнойным. Одновременно в коре головного мозга при менингите иногда появляются участки размягчения и нагноения. Таким образом, каждый менингит является по существу менингоэнцефалитом.
Твердая мозговая оболочка при менингите также становится гиперемированной, напряженной. Воспаление оболочек при менингите чаще выражено на основании мозга (базальный менингит), иногда распространяется на полушария большого мозга или ограничивается только ими. Еще реже менингит наблюдается лишь в области мозжечка, иногда распространяясь и на оболочки спинного мозга. В особо тяжелых случаях гнойный воспалительный процесс при менингите распространяется на все субарахноидальное пространство большого мозга, мозжечка и спинного мозга.

Симптомы и течение менингита при отите
Головная боль при менингите часто интенсивная, почти постоянна. Головная боль при менингите появляется раньше других симптомов. Вначале головная боль при менингите может ограничиться областью затылка или лба, затем стать диффузной. Очень часто головная боль при менингите сопровождается тошнотой и рвотой.
Температура при менингите повышается до 39-40° С и выше и имеет характер continua. Пульс обычно ускорен, но иногда отмечается брадикардия. Общее состояние пациента при менингите тяжелое, лицо часто бледное, землистого цвета, измученное, язык сухой.
Сознание пациента при менингите спутанное, переходящее в бред. Больной апатичен, нередко отмечается двигательное возбуждение, усиливающееся при посторонних раздражениях (звук, свет). Характерно положение больного с запрокинутой головой, согнутыми в коленях ногами для устранения излишнего натяжения твёрдой мозговой оболочки.
Ригидность мышц затылка и симптомы Кернига и Брудзинского всегда выражены у пациента при менингите. Иногда отмечаются пирамидные симптомы (патологические рефлексы — Бабинского, Оппенгейма, Гордона и др.). Изредка бывают судороги конечностей.
Нередко при базальном менингите наблюдаются параличи отводящего, а иногда глазодвигательного и других черепных нервов. Редко возникают очаговые мозговые симптомы, заставляющие прибегнуть к безуспешной и даже небезвредной пункции мозга.
Спинномозговая жидкость (ликвор) выходит при люмбальной пункции обычно под значительно повышенным давлением. Она теряет прозрачность, становится мутной, иногда почти чисто гнойной. Плеоцитоз в ликворе значительно варьирует от умеренного повышения до такого числа клеток, которое невозможно сосчитать. Обычно преобладают нейтрофилы, при дальнейшем благоприятном течении отмечается лимфоцитарная реакция, но такое соотношение клеточных элементов далеко не постоянно, особенно при лечении антибиотиками. Содержание белка, как правило, повышено, часто значительно. Процентное содержание сахара и хлоридов, наоборот, понижено.

Люмбальную пункцию (ЛП ) проводят для измерения ликворного давления, исследования проходимости субарахноидального пространства спинного мозга, определения цвета, прозрачности и состава спинномозговой жидкости.
Использование антибиотиков привело к значительным изменениям клиники менингита. Симптомы стали стертыми, иногда даже невыраженными, другой характер приобрело течение менингита. Так, нередки случаи менингита с субфебрильной или нормальной температурой, с легкой головной болью, с мало выраженными менингеальными симптомами, нарушением сознания и другими мозговыми симптомами при общем удовлетворительном или даже хорошем состоянии. Нередко отмечающиеся значительные модификации в спинномозговой жидкости (снижение плеоцитоза, изменение клеточного состава в сторону лимфоцитоза и т. д.) и гемограмма также маскируют истинную картину заболевания.
Течение менингита при своевременном хирургическом вмешательстве, отсутствии других осложнений и рациональном применении антибиотиков и сульфаниламидных препаратов большей частью благоприятное, чаще всего заболевание по истечении 3-4 недели заканчивается выздоровлением. Однако наблюдается затяжное течение (до нескольких месяцев), обычно интермиттирующего характера (так называемые рецидивирующие менингиты). Эта форма менингита обусловлена рядом факторов:
- оставшиеся после операции на ухе гнойные очаги в лабиринте или верхушке пирамиды височной кости
- глубокие эпидуральные абсцессы
- отграниченные скопления гноя в субарахноидальном пространстве, не поддающиеся вследствие фибринозно-пластического осумкования воздействию антибиотиков (они же могут обусловить очаговые мозговые симптомы)
При перемежающемся течении менингита с рядом вспышек и затуханий постепенно возрастает резистентность бактерий. Прогноз при таком течении менингита большей частью плохой. Смертельный исход свойствен также гематогенной форме менингита, при которой нередко симптомы так молниеносно нарастают, что на вскрытии не удается установить видимых (макроскопически) изменений оболочек.
Диагностика менингита при отите
При наличии характерных менингеальных симптомов и картины спинномозговой жидкости диагноз несложен. Установив менингит, необходимо выяснить ряд обстоятельств — связан ли он с заболеванием уха, не является ли он эпидемическим цереброспинальным или туберкулезным менингитом, не является ли он следствием другого отогенного внутричерепного осложнения (например, экстрадурального или мозгового абсцесса).
Острое воспаление или обострение хронического гнойного воспаления среднего уха говорит в пользу отогенного характера менингита. Нахождение в спинномозговой жидкости менингококков или туберкулезных микобактерий выявляет характер менингита. Однако микобактерии высеваются при туберкулезе далеко не всегда. Для туберкулезного менингита характерны прозрачная жидкость, вытекающая при пункции под высоким давлением, лимфоцитарная реакция ликвора, выпадение пленки фибрина. Уточнению диагноза способствует выявление органного туберкулеза. Однако это удается далеко не всегда, а в то же время клиническое течение туберкулезного менингита может быть атипичным.
Наряду с туберкулезным менингитом следует дифференцировать отогенный менингит от цереброспинального менингита. Последний характеризуется внезапным началом, отсутствием всякой продромы, которая при отогенном менингите может быть в виде постепенно нарастающей головной боли за несколько дней до развитой картины заболевания. Если при гнойном менингите имеется картина острого среднего отита или обострения хронического гнойного среднего отита не следует медлить с операцией на ухе.
В преобладающем большинстве случаев операционные находки подтверждают правильность принятого решения. На операции чаще всего удается обнаружить и другие внутричерепные осложнения, если менингит возник на их почве. При отсутствии таких находок необходимо тщательное наблюдение за неврологической симптоматикой и динамикой изменений спинномозговой жидкости, учитывая прежде всего возможность нераспознанного абсцесса мозга. Подозрение в отношении абсцесса мозга должно возникнуть при отсутствии улучшения неврологического статуса с одновременной тенденцией к нормализации ликвора и при белковоклеточной диссоциации в ликворе (повышенное содержание белка при незначительном плеоцитозе).
Лечение менингита при отите
Операция на височной кости (простая или общеполостная в зависимости от характера отита) с широким обнажением твердой мозговой оболочки в средней и задней черепной ямке. При выявлении сопутствующего осложнения (эпидуральном или субдуральный абсцесс, абсцесс мозга, тромбофлебит сигмовидного синуса) производится соответствующее вмешательство. Вмешательство на лабиринте или верхушке пирамиды даже при осложнении необязательно. Очень часто явления гнойного лабиринтита или петрозита ликвидируются после обычной операции на височной кости и медикаментозного лечения. Однако при отсутствии успеха или неполном эффекте указанное вмешательство на лабиринте или верхушке пирамиды следует произвести.
Послеоперационное лечение состоит в применении антибиотиков и сульфаниламидов. Лечение необходимо сочетать с пероральным приемом нистатина во избежание развития кандидоза (по 500 000 ЕД 3-4 раза в день) и витаминотерапией (аскорбиновая кислота и комплекс витаминов группы В).
Для снижения внутричерепного давления проводят дегидратацию: 10-15 мл 25% раствора магния сульфата в/м, 10 мл 2,4% раствора эуфиллина в/в, капельно, 1-2 мл 2% раствора лазикса в/в или в/м или фуросемид (1-2 таблетки) внутрь. Производят люмбальные пункции (в тяжелых случаях через 2-3 дня, при начинающейся санации ликвора — через 4-5 дней), причем выпускается умеренное количество ликвора. При выраженном клиническом улучшении и приближении к нормализации ликвора пункции прекращают. В тяжелых случаях после удаления жидкости эндолюмбально вводят антибиотики.
При особо тяжелых формах менингита с угрожающим нарастанием внутричерепного давления, не поддающимся указанному лечению, в дополнение к произведенной операции показано вскрытие боковой цистерны мозга. В тяжелых случаях менингоэнцефалита применяют также введение антибиотиков через просвет сонных артерий.
Профилактика отогенного менингита. Борьба с ушным менингитом
Комбинированное лечение отогенного менингита. Эффективные комбинации антибиотиков в прошлом
В лечении отогенного менингита наиболее эффективным оказывается комбинированное применение пенициллина со стрептомицином. Такое сочетание антибиотиков значительно расширяет диапазон их действия. Стрептомицин обладает более широким антибактериальным спектром, нежели пенициллин. Пенициллин действует в основном на грамположительную флору, в то время как стрептомицин действует и на грамотрицатель-ную. Поэтому стрептомицин находит применение при ряде инфекционных заболеваний, на которые не оказывают эффекта другие антибиотики.
Комбинированный способ лечения пенициллином и стрептомицином особенно показан в тяжелых случаях менингита. Применение обоих антибиотиков при менингите очень важно. Один антибиотик усиливает антибактериальные свойства другого и в итоге совместного действия они дают большой терапевтический эффект. Кроме того, одновременное применение указанных антибиотиков предотвращает возможность образования резистентных к действию каждого из них в отдельности микроорганизмов. Такой способ лечения значительно сокращает период болезни, делает его более коротким, приводит к быстрому снижению явлений интоксикации.
Методика лечения пенициллином и стрептомицином установлена эмпирически. Она состоит в введении пенициллина в количестве 800 тыс. — 1 млн. ЕД в сутки, а стрептомицина 0,5—1 млн. ЕД. Указанные препараты вводятся внутримышечно: пенициллин через каждые 3 к, а стрептомицин в зависимости от его дозировки 1 или 2 раза в день. Детям до 3 лет стрептомицин назначается по 200—250 тыс. ЕД в сутки, от 4 до 7 лет — по 250—300 тыс. ЕД в сутки, от 8 лет и старше по 300— 500 тыс. ЕД в сутки.
Если при пенициллинотерапии длительность лечения, по нашим данным, равняется в среднем 8—12 дням, то комбинированное применение пенициллина и стрептомицина при менингите ликвидирует болезненный процесс приблизительно в течение 4—8 дней.
Эффективна также, по нашим наблюдениям, комбинированная терапия менингита стрептомицином или пенициллином в сочетании с каким-нибудь антибиотиком группы тетрациклинов.
Действие биомицина и тетрациклина распространяется как на грамположительную, так и на грамотрица-тельную флору. При комбинированном применении упомянутых антибиотиков стрептомицин и пенициллин вводятся внутримышечно в дозировке, указанной нами выше, а биомицин внутрь 4 раза в день по 200 тыс. ЕД. Суточная доза биомицина для взрослого человека равна приблизительно 800 тыс.— 1 млн. ЕД. Для детей биомицин назначается из расчета 25 тыс. ЕД на 1 кг веса в сутки. Результаты лечения отогенного менингита двумя или тремя антибиотиками благоприятны. Они дают хороший терапевтический эффект и приводят к быстрому излечению заболевания.
Однако назначение биомицина не всегда возможно. В тех случаях, когда менингит сопровождается тошнотой и особенно рвотой, его применение нецелесообразно. Пероральное введение его усиливает указанные явления.
Тетрациклин вводится перорально или внутримышечно. Взрослым больным он вводится по 100 тыс. ЕД, а детям до 1 года— 10 тыс. ЕД, от 1 до 5 лет — 20 тыс. ЕД, старше 5 лет — 30 тыс. ЕД. Тетрациклин вводится 2—3 раза в сутки. После 5—7 дней применения делается перерыв на 4—7 дней.
Лечение антибиотиками должно быть динамичным в том смысле, что если назначенный антибиотик не дает эффекта, то он должен быть заменен другим.
Если комбинированное лечение антибиотиками оказывается неэффективным, то нужно изменить их сочетание.
Отсутствие эффекта от антибиотикотерапии указывает на резистентность флоры, вызвавшей отогенный менингит, к действию назначенных антибиотических веществ. Поэтому важно определить чувствительность флоры патологического содержимого уха к различным антибиотикам или еще лучше (где это возможно) возбудителя, выделенного из спинномозговой жидкости. Не ожидая результатов упомянутых исследований, лечение больных отогенным менингитом должно начинаться с момента установления диагноза заболевания.
Эффективность лечения отогенного менингита зависит от многих факторов: 1) давности заболевания и времени начала лечения, 2) особенности течения болезни, 3) сочетания менингита с другими внутричерепными осложнениями и т. п.
Информация на сайте подлежит консультации лечащим врачом и не заменяет очной консультации с ним.
См. подробнее в пользовательском соглашении.
Профилактике отогенных внутричерепных осложнений уделяется большое внимание в специальной литературе. Как справедливо замечает В. Н. Черниговский, «задачи профилактики тесно переплетаются с задачами лечения». Это положение особенно применимо к заболеваниям уха. Выявлению, лечению и профилактике воспалительных заболеваний среднего уха, ведущих к развитию менингита, посвящены работы А. А. Бекрицкого, В. И. Воячека, А. И. Коло.мийченко, К. Ю. Кононович, Б. С. Преображенского и др.
Профилактика отогенных менингитов складывается из ряда мероприятий. К ним относятся: а) активное выявление больных с острыми и хроническими средними отитами и планомерное их лечение; б) санация верхних дыхательных путей, особенно в детском возрасте; в) диспансеризация больных с хроническими гнойными средними отитами; г) массовые мероприятия, направленные к ликвидации инфекционных заболеваний (скарлатина, корь и т. п.), которые также ведут к профилактике средних отитов.
Профилактика отогенных гнойных менингитов должна быть направлена в сторону активного выявления больных с острыми и хроническими гнойными отитами и планомерного их лечения. Своевременное и рациональное лечение больных с острыми и хроническими .отитами является в одно и то же время профилактикой отогенного менингита.
Выявление больных с острыми отитами не представляет особых трудностей. Эти больные из-за болевых реакций вынуждены обращаться за врачебной помощью. Больные острыми отитами должны быть на учете лечебных учреждений до полного их выздоровления. Лечение их все время должно проводиться под руководством и контролем врача. Рациональное и своевременное лечение больных острыми отитами очень важно. Пользуясь современными средствами (антибиотики и др.) и рационально используя их, можно в большинстве случаев добиться полной ликвидации воспалительного процесса. Санация таких больных является мерой, предотвращающей переход острого отита в хронический.
Большое значение имеет профилактика острых отитов при инфекционных заболеваниях (скарлатина, корь и пр.). Современное лечение скарлатины, кори и других инфекционных болезней одновременно является профилактикой различных осложнений, в том числе и воспалений среднего уха.

В порядке профилактики больные с указанными инфекционными заболеваниями подлежат систематическому обследованию со стороны отоларинголога. Целью этих осмотров является активное выявление заболеваний среднего уха. Опыт показывает, что в настоящее время скарлатина и корь значительно реже осложняются отитами, кроме того, средние отиты протекают легче, без обширных деструкции, которые были так характерны для них еще совсем недавно (10—15 лет назад).
Большое значение в деле профилактики острых средних отитов имеет санация верхних дыхательных путей. Патология верхних дыхательных путей (острые и хронические риниты, синуиты, аденоидные разращения, фарингиты, воспалительные заболевания лимфааденоидной ткани и др.), как известно, играет большую роль в патогенезе острых заболеваний среднего уха. Необходимо систематически проводить осмотр детей в яслях, Детсадах, школах, детских домах и детских больницах. Дети с выявленными заболеваниями должны подвергнуться соответствующему лечению.
Что касается больных с хроническими гнойными средними отитами, то они, независимо от возраста и профессии, подлежат диспансеризации.
Больные с хроническими средними отитами должны быть на учете соответствующих лечебных учреждений, где они периодически осматриваются и получают лечение. Еще эффективнее лечение, проводимое непосредственно в поликлинике. Лечение, проводимое самим врачом, более действенно. Больных, у которых отиты упорно не поддаются консервативному лечению в условиях поликлиники, желательно направлять в стационары. В стационары направляются также больные, нуждающиеся в хирургическом лечении (удаление ушных полипов и т. п.). Для успешного лечения этой категории больных многие из них должны подвергнуться санации верхних дыхательных путей. Заболевания верхних дыхательных путей поддерживают воспалительный процесс в ухе и являются препятствием для успешной терапии.
Диспансеризация больных хроническими гнойными средними отитами имеет большое значение для профилактики внутричерепных осложнений, она имеет также большое значение с точки зрения сохранения слуха и работоспособности. Все это необходимо для сохранения здорового поколения.
Если хронический гнойный средний отит, осложненный холестеатомой или кариесом, дает какие-либо клинические проявления в виде головной боли, головокружения, нистагма, боли в ухе, то такие больные должны быть немедленно отправлены на стационарное лечение.
Диспансеризация больных, страдающих хроническими гнойными средними отитами, давно назрела, а реализация ее вполне возможна. Специализированная помощь по отоларингологии в настоящее время значительно приближена к населению периферии; качество ее все время улучшается. По приказу Министра здравоохранения СССР за № 278 в каждой сельской больнице, имеющей 50 и больше коек, вводится должность врача отоларинголога. Этот приказ имеет очень большое значение для улучшения постановки специализированной помощи на селе. Реализация приказа обеспечивает сельское население отоларингологической помощью и проведением мероприятий, связанных с диспансеризацией и плановым лечением больных с хроническими гнойными заболеваниями среднего уха.
IX Международная студенческая научная конференция Студенческий научный форум - 2017

ОТОГЕННЫЙ МЕНИНГИТ: КЛИНИКА, ДИАГНОСТИКА, ЛЕЧЕНИЕ, ПРОФИЛАКТИКА.
Текст работы размещён без изображений и формул.
Полная версия работы доступна во вкладке "Файлы работы" в формате PDF
Актуальность: Отогенный менингит является часто хроническим и реже острым осложнением гнойного отита среднего уха[1,4]. Чаще болеют дети грудного возраста и молодые люди, что плохо влияет на их дальнейшую работоспособность и жизнь в социуме, и может привести к летальному исходу[2]. Отогенный менингит следует всегда рассматривать как гнойный; Его нужно отличать от явлений раздражения оболочек, так же его необходимо дифференцировать от эпидемического цереброспинального и туберкулезного менингита. Все это требует современных методов диагностики и своевременного медикаментозного обеспечения, что значительно уменьшает показатель летальности и повысит качество жизни больного[3].
Цель: Проанализировать современные методы диагностики отогенного менингита и его лечение.
Клиническая картина является важной частью диагностики заболевания. В клинической картине отогенного менингита различают общие симптомы инфекционного заболевания, менингеальные, мозговые и в ряде случаев очаговые.
Общие симптомы — повышение температуры тела, изменения со стороны внутренних органов (сердечно-сосудистой системы, дыхания, пищеварения), ухудшение общего состояния больного.
Заболевание начинается обычно с подъема температуры до 38—40 °С. Поскольку менингит развивается во время обострения хронического или острого гнойного среднего отита, этот подъем чаще возникает на фоне субфебрильной температуры. Температурная кривая наиболее часто носит постоянный характер с небольшими колебаниями в пределах до 1 °С в течение суток. Реже наблюдается ремиттирующее течение лихорадки, и в этих случаях необходимо исключить наличие синус- тромбоза и сепсиса. Своевременное начало лечения антибиотиками приводит к довольно быстрому снижению температуры, поэтому длительность температурной кривой обычно определяется интенсивностью терапии.
Возможно иногда и менее острое начало менингита с температурой, не превышающей субфебрильной или в редких случаях даже нормальной. Обычно такая атипичная температура наблюдается при измененной иммунологической активности у пожилых ослабленных больных, у больных диабетом и беременных женщин.
Изменения сердечно-сосудистой системы определяют выраженностью интоксикации. Обычно наблюдается тахикардия, соответствующая температуре либо несколько превышающая ее. Сердечные тоны приглушены, на ЭКГ — явления нарушения трофики. Дыхание учащенное, но ритмичное. Язык сухой, может быть обложен налетом. Кожные покровы бледные. Общее состояние больного, как правило, тяжелое и только в редких случаях (не более чем в 2—3 %) может быть охарактеризовано как относительно удовлетворительное. Следует отметить, что не всегда тяжесть состояния при первоначальном осмотре соответствует изменениям в цереброспинальной жидкости: оно может быть тяжелым при относительно небольшом цитозе (250—300 клеток в 1 мкл).
Менингеальные симптомы — головная боль, рвота, менингеальные знаки, нарушение сознания.
Самым ранним и частым симптомом служит интенсивная головная боль. Причина ее --- повышение внутричерепного давления, растяжение твердой мозговой оболочки и раздражение окончаний тройничного нерва. Головная боль усиливается при любом внешнем раздражении --- тактильном, зрительном, слуховом. Поэтому больному следует создать условия максимального покоя, исключающего такие раздражители. Больного беспокоят тошнота и рвота, не связанныес приемом пищи, т.е. центрального генеза. Рвота объясняется раздражением ядер n. vagus.
Ригидность мышц затылка и симптомы Кернига и Брудзинского всегда выражены. Иногда отмечаются пирамидные симптомы (патологические рефлексы — Бабинского, Оппенгейма, Гордона и др.). Изредка бывают судороги конечностей. Нередко при базальном менингите наблюдаются параличи отводящего, а иногда глазодвигательного и других черепных нервов. Редко возникают очаговые мозговые симптомы, заставляющие прибегнуть к безуспешной и даже небезвредной пункции мозга. Спинномозговая жидкость выходит при люмбальной пункции обычно под значительно повышенным давлением.
Два основных симптома (Кернига и ригидность затылочных мышц) обычно соответствуют по их выраженности тяжести менингита, другие могут проявляться неоднозначно и не всегда достигать значительной степени и соответствовать тяжести менингита и изменениям в спинномозговой жидкости. Поэтому при подозрении на менингит наличие даже незначительных менингеальных знаков является безусловным показанием к люмбальной пункции.
Уже в самом начале заболевания отмечаются изменения сознания: вялость, оглушенность, заторможенность при сохраненной ориентировке в месте, времени и собственной личности. Через несколько часов или дней нередко наступает затемнение сознания, иногда вплоть до сопора в течение короткого времени. Реже заболевание начинается с потери сознания, развивающейся одновременно с подъемом температуры. Возможно психомоторное возбуждение, сменяющееся угнетением и сонливостью.
Очаговые симптомы могут быть разделены на две группы: симптомы поражения вещества мозга и черепных нервов. Появление очаговых симптомов требует дифференцирования от абсцесса мозга. Черепные нервы вовлекаются в процесс при базальной локализации менингита. Обычно поражаются глазодвигательные нервы, из них наиболее часто — отводящий, реже — глазодвигательный, еще реже — блоковый нервы. Появление этих и других (см. «Абсцессы мозга») очаговых симптомов не зависит от тяжести поражения оболочек.
Глазное дно. В больш инстве случаев отогенных менингитов глазное дно не изменено. У 4—5 % больных в остром периоде отмечаются различные изменения глазного дна: незначительная гиперемия дисков зрительных нервов, легкая стушеванность их границ, расширение и напряжение вен, обусловленные значительным повышением внутричерепного давления. Имеет значение, очевидно, и локализация экссудата на основании мозга.
В крови во всех случаях наблюдается нейтрофильный лейкоцитоз. СОЭ увеличена от 30—40 до 60 мм/ч. Иногда отмечается диссоциация между высоким лейкоцитозом и отсутствием значительного увеличения СОЭ.
Изменения в цереброспинальной жидкости. Всегда определяется высокое ликворное давление — от 300 до 600 (при норме до 180) мм вод.ст. Цвет цереброспинальной жидкости изменен от легкой опалесценции до молочного вида, часто он приобретает вид мутной зеленовато-желтой гнойной жидкости. Цитоз различен — от 0,2-109/л до 30,0-109/л клеток. Во всех случаях преобладают нейтрофилы (80—90 %). Нередко плеоцитоз настолько велик, что число клеток не поддается подсчету. Оно зависит и от времени люмбальной пункции: в самом начале заболевания цитоз может быть меньше и не всегда соответствует тяжести состояния больного. В ряде случаев низкий плеоцитоз при тяжелом состоянии больного является прогностически неблагоприятным, поскольку это признак ареактивности организма. Количество белка увеличено иногда до 1,5— 2 г/л, но не всегда пропорционально плеоцитозу. Хлориды в цереброспинальной жидкости остаются в пределах нормы или их содержание несколько снижено. Количество сахара нормально или снижено при нормальном его содержании в крови. Значительное же снижение сахара также является прогностически неблагоприятным признаком (норма 60—70 %, снижение до 34 %). Так же при подозрении отогенного менингита нужно исследовать спинномозговую жидкость на содержание микроорганизмов и их чувствительность к антибиотикам[1,4].
Обязательным компонентом лечения больных с отогенными внутричерепными осложнениями является хирургическая элиминация очага первичного воспаления в среднем ухе. Подчеркивается значение раннего отохирургического вмешательства . В зависимости от анатомических условий, характера и распространенности патологического процесса на основание черепа в этих случаях применяются открытая или закрытая техника вмешательства, тщательное удаление холестеатомы.
При отогенных интракраниальных осложнениях антибактериальное лечение должно начинаться как можно раньше, практически всегда - до верификации возбудителя. В этих случаях выбор антибиотика осуществляется с учетом эпидемиологической информации - структуры этиологически значимых возбудителей, распространенности резистентных штаммов, высокой вероятности смешанной аэробно-анаэробной инфекции .
Эффективность этиотропной терапии больных с внутричерепными отогенными осложнениями во многом зависит от применения антибактериальных препаратов, активных в отношении анаэробов, высеваемость которых при отогенных абсцессах мозга, менингите может достигать 80-90%. Доказанной эффективностью в отношении анаэробной инфекции обладает метронидазол, бактерицидная концентрация которого в спинномозговой жидкости достигается уже через час после внутривенного введения одной дозы препарата .
В структуре этиологически значимых микроорганизмов при интракраниальной отогенной инфекции (менингит, абсцесс мозга) преобладают пенициллин-резистентные штаммы. В связи с этим важное место в лечении таких больных занимают карбапенемы - имипенем, меропенем . Отмечается высокая активность меропенема в отношении S. pneumoniae, Н. influenzae, хорошее проникновение в спинномозговую жидкость, отсутствие в отличие от имипенема токсического действия на центральную нервную систему.
При идентификации грамположительной кокковой флоры - стрептококков, полирезистентных штаммов стафилококка препаратом выбора явлется ванкомицин. Однако ванкомицин характеризуется недостаточным пассажем через гематоэнцефалический барьер, в связи с чем целесообразна его комбинация с β-лактамами .
Длительность антибиотикотерапии определяется на основании результатов непрерывного мониторинга клинических симптомов заболевания, данных систематических КТ и МРТ.
Таким образом, эффективность лечения этой категории больных в значительной степени зависит от своевременной диагностики интракраниальных осложнений у пациентов с воспалительными заболеваниями уха, сбалансированного подхода при определении показаний к хирургической элиминации патологического процесса с учетом особенностей нозологической формы и стадии болезни, тяжести состояния больного. С точки зрения эволюции взглядов на антибактериальную терапию при отогенных внутричерепных осложнениях следут отметить расширение ее возможностей и важность использования в комплексном лечении таких пациентов антибиотиков, активных в отношении этиологически значимых возбудителей и обладающих оптимальными фармакокинетическими свойствами. [2,5]
ВыводНесмотря на все методы диагностики и лечения существует ряд причин для их усовершенствования:
1. Частота отогенных внутричерепных осложнений не имеет тенденции к снижению. Распространенность данной патологии среди взрослого населения Красноярского края и Санкт-Петербурга составляет 0,32 на 100 000 населения. Заболеваемость внутричерепными осложнениями среди пациентов, страдающих гнойным средним отитом и находящихся на лечении в ЛОР-стационарах взрослой сети — 3,2%.
2. В структуре внутричерепных осложнений преобладал менингит — 42,5% (гнойный — 38,7%, серозный — 3,8%);
3. В ходе проведенного многоцентрового исследования выявлены высокие показатели больничной летальности при отогенной воспалительной внутричерепной патологии — 20,8%, что сравнимо с уровнем летальности при указанной патологии во второй половине прошлого столетия. Главными причинами смерти пролеченных больных с отогенными внутричерепными осложнениями были отек головного мозга с развитием дислокационного синдрома и сепсис.
4. Наличие отогенных внутричерепных осложнений требует мультидисциплинарного подхода к совершенствованию процесса их диагностики и лечения на всех уровнях оказания медицинской помощи данной категории больных. Причиной этому служит то, что многие результаты диагностики положительны и при других заболеваниях нервной системы и тем самым затрудняется их дифференциация[3]
1. Е. Ю. Белокопытова (Российский научно-практический центр аудиологии и слухопротезирования ФМБА России, Москва, Россия, 117513,) В. И. Федосеев (Российский научно-практический центр аудиологии и слухопротезирования ФМБА России, Москва, Россия, 117513)В. А. Плешков(Российский научно-практический центр аудиологии и слухопротезирования ФМБА России, Москва, Россия, 117513); - «Лечение острого воспаления наружного и среднего уха», Журнал:Вестник оториноларингологии. 2014;(3): 54-58
2. Б. У. Джафек, Э.К. Старк. «Секреты оториноларингологии» Пер. с английского М. – СПб.: «Издательство БИНОМ» - «Невский диалект», 2001, с. 106-117.
3. С. Я. Косяков (Кафедра оториноларингологии РМАПО, Москва), Е. В. Носуля (Кафедра оториноларингологии РМАПО, Москва), Б. Перич (Кафедра оториноларингологии РМАПО, Москва); «Отогенные внутричерепные осложнения: актуальные вопросы диагностики и лечения». Журнал:Вестник оториноларингологии. 2014;(1): 64-69
4. В. Т. Пальчун, М. М. Магомедов, Л.А Лучихин. Оториноларингология. 2-е издание исправленное и дополненное. М: ГОЭТАР- Медиа 2011.
5.Ю. К. Янов (Санкт-Петербургский научно-исследовательский институт уха, горла, носа и речи Минздрава России, Санкт-Петербург, Россия, 190013), А. А. Кривопалов( Санкт-Петербургский научно-исследовательский институт уха, горла, носа и речи Минздрава России, Санкт-Петербург, Россия, 190013) и др.; -Журнал:Вестник оториноларингологии. 2015;80(5): 23-29.
Отогенный менингит. Причины, симптомы и лечение
Диагноз «отогенный менингит» в развернутом виде означает «воспаление мягких мозговых оболочек, обусловленное распространением инфекции из уха».
Очевидно, что такая ситуация относится к числу наиболее тяжелых осложнений при отитах, т.е. инфекционно-воспалительных процессах в различных приемных, звукопроводящих и резонаторных отделах органов слуха. Непосредственная близость к внутричерепным структурам, обилие кровеносных сосудов и лимфоузлов создают предпосылки для проникновения и экспансии инфекции тем или иным путем (гематогенным, лимфогенным, контактным).
Чаще всего заболевают дети, страдающие гнойным средним отитом (сальпингоотитом), причем чем младше ребенок, тем выше риск отогенного менингита, – причина в инфантильности строения, неполной анатомической сформированности пазух и полостей в черепных костях. Эпидемиологические данные противоречивы (в частности, одни источники связывают отогенный менингит преимущественно с острым, другие – с хроническим средним отитом).
2. Причины
Отогенный менингит и/или менингоэнцефалит (т.е. воспаление мозговых оболочек, осложненное распространением инфекции на вещество мозга) чаще вызывается бактериальными патогенами, однако возможна и вирусная этиология, – как правило, на фоне сезонных эпидемических ОРВИ. Ведущими факторами риска, помимо детского возраста, выступают общая иммунная слабость, индивидуальные анатомические особенности и неадекватное лечение отита (или отсутствие таковой терапии). Во многих случаях отогенный менингит носит вторичный характер по отношению к отогенному же абсцессу головного мозга.
3. Симптомы и диагностика
Клиническая картина отогенного менингита полиморфна, она включает несколько стадий и сочетает общие инфекционно-токсические симптомы со специфическими менингизмами, или менингеальными знаками. Так, резко повышается температура тела, больной испытывает сильную головную боль, тошноту, светобоязнь; отмечается тахикардия при ослабленном наполнении пульса. Нередко больной принимает характерную позу лежа на боку с подтянутыми к животу ногами и запрокинутой головой.
К наиболее типичным симптомам относится стойкое напряжение затылочных мышц, светобоязнь, искажения чувствительности. Иногда наблюдаются нарушения психической деятельности по галлюцинаторно-бредовому типу, с последующей амнезией «психотического» отрезка времени, либо сопорозное состояние сознания.
Медицине известно множество признаков (симптомы Брудзинского, Бехтерева, Кернига и др.) и разработаны четкие критерии, позволяющие уверенно диагностировать менингит уже на этапе клинического осмотра. Проводится рефлексологическое исследование, собирается анамнез, в том числе о состоянии ЛОР-органов (как правило, к этому моменту отит уже выявлен и подтвержден оториноларингологом). Назначаются лабораторные анализы, пункционным способом отбирается образец спинномозговой жидкости, исследуется глазное дно.
4. Лечение
Методом выбора, как правило, является агрессивное консервативное лечение. Одной из первоочередных задач выступает обеспечение вентиляции и дренирования среднего уха (через хирургический прокол в барабанной перепонке). Назначают антибиотики широкого спектра действия в эффективных дозировках, противовоспалительные, жаропонижающие, антипсихотические средства по показаниям. Примерно в 10-20% случаев необходимо экстренное радикальное хирургическое вмешательство.
В настоящее время летальные исходы при отогенном менингите стали редкостью, однако встречаются они и сегодня – как правило, в случае запоздалого обращения за помощью, когда, например, вялая симптоматика хронического среднего отита обретает характер «привычного» дискомфорта и не связывается больным (или родителями, если речь идет о ребенке) с появившимися менингеальными знаками, а последние, в свою очередь, не распознаются вовремя как мозговые симптомы. Также исход может оказаться неблагоприятным в случае стремительного развития мозгового воспаления (молниеносная форма отогенного менингита). Поэтому при возникновении описанных выше симптомов в любом их сочетании «Скорая помощь» должна быть вызвана безотлагательно.
Читайте также:
- Механизмы накопления жировой ткани у плода
- Гемодинамика при воздушных ваннах. Теплообмен под воздушной ванной
- Развитие восстановительных операций при отоспонгиозе. Фенестрация при отосклерозе
- Нарушение секреции желудка. Органическая патология вне желудка
- КТ, МРТ при кисте межмыщелковой вырезки коленного сустава
